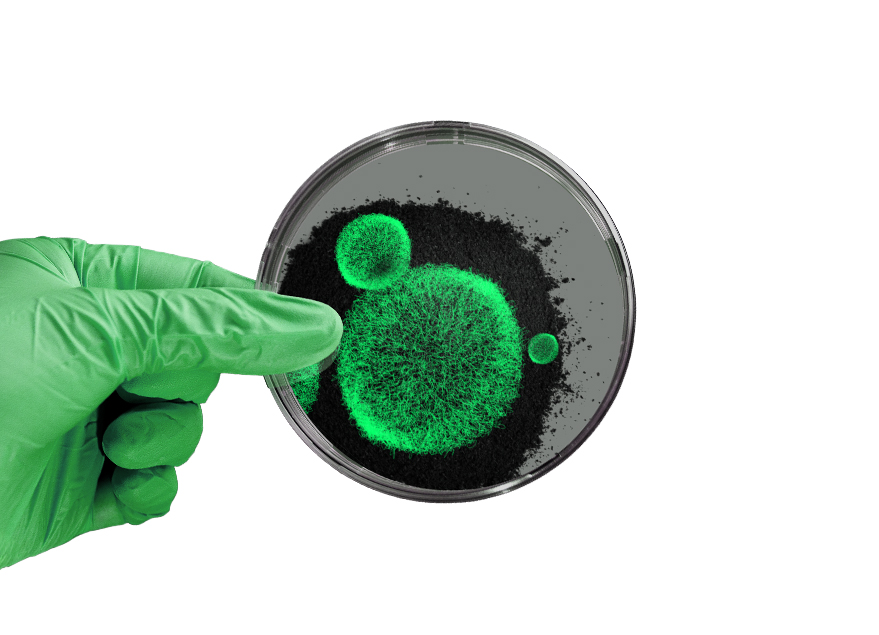

Benefits
for all!
Be part of the virtuous circle
Tyre Recycling Solutions
TRS proprietary technologies give Recyclers optimal value creating opportunities. Gain market value and tap new profit channels together as our Partner. Increase your profitability by partnering with TRS.

Compounding Solutions
Engineered to deliver groundbreaking compounding applications, TyreXol™ is a versatile, sustainable and cost effective recycled Rubber Powder. TyreXol™ activated powders customised by our Formulation Experts provide cutting edge performance to polymer products in multiple market segments.